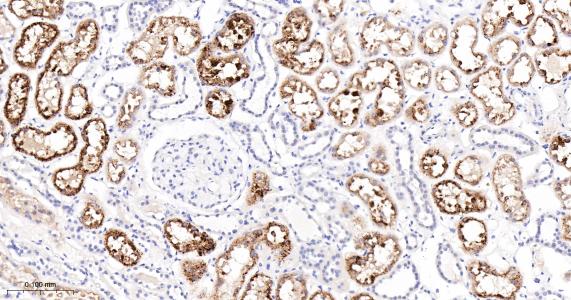
磷酸肌肽3激酶调控亚基4重组兔单抗

Regulatory subunit of the PI3K complex that mediates formation of phosphatidylinositol 3-phosphate; different complex forms are believed to play a role in multiple membrane trafficking pathways: PI3KC3-C1 is involved in initiation of autophagosomes and PI3KC3-C2 in maturation of autophagosomes and endocytosis. Involved in regulation of degradative endocytic trafficking and cytokinesis, probably in the context of PI3KC3-C2.

| 应用 | 已检合格种属 | 预测种属 | 推荐稀释比例 |
|---|---|---|---|
| WB | Human, Mouse | Rat | 1:500-2000 |
| IHC-P | Human, Mouse, Rat | 1:100-500 | |
| IHC-F | Human, Mouse, Rat | 1:100-500 | |
| IF | Human, Mouse, Rat | 1:100-500 | |
| Flow-Cyt | Human, Mouse, Rat | 1:50-100 | |
| ICC/IF | Human, Mouse, Rat | 1:50-200 |
交叉反应: Human, Mouse, Rat
暂无相关产品